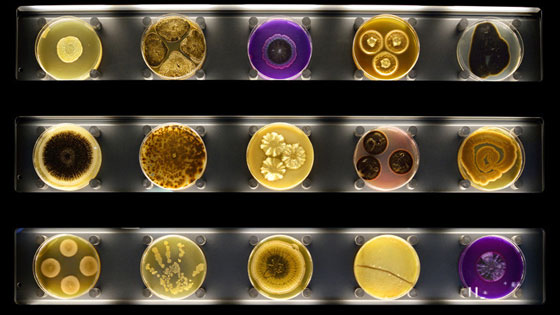

يؤكد علماء هولنديون أن 80 مليون من البكتيريا تنتقل من عشيق إلى آخر أثناء قبلة مدتها عشر ثوان. بالإضافة إلى ذلك وجد العلماء أن مستوطنات متشابهة من المكروبات تعيش في أفواه الأشخاص الذين يقبلون بعضهم البعض تسع مرات يوميا على الأقل. فحص العلماء من هولندا 21 زوجا من المتطوعين الذين أشاروا إلى عدد قبلاتهم اليومية ومددها.
كما أخذ العلماء عينات من لعاب تجاويف أفواههم لمعرفة ماهية مستوطنات البكتيريا العائشة على ألسنتهم وفي لعابهم. ويقول العلماء انه كلما تعددت القبلات تتشابه اكثر فأكثر مستوطنات البكتيريا. وتعتبر قبلات الحب الحارة التي يتحقق فيها تماس كامل بين لساني الشريكين وتبادل باللعاب، تعتبر ميزة فريدة من نوعها لدى البشر. تنتشر مثل هذه القبلات ضمن 90% من الثقافات البشرية.
ولكن العلماء يشيرون إلى أن الزيادة في تعدد القبلات لا تؤثر كثيرا على تنوع مستوطنات البكتيريا العائشة على لسان الشخص، وإنما نمط الحياة وتفضيل بعض أنواع الطعام ومراعاة القواعد الصحية تعتبر العوامل الأكثر تأثيرا في هذا المجال.















